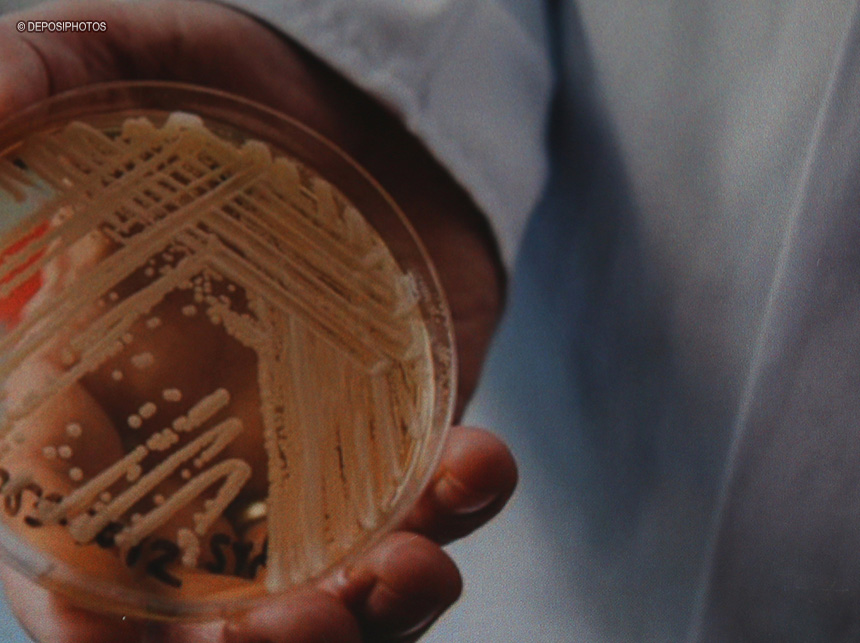
São Paulo confirma primeiro caso de superfungo Candida auris

O governo do Espírito Santo proibiu, por tempo indeterminado, o acesso ao Arquipélago das Três Ilhas e às demais ilhas da Área de Proteção Ambiental (APA) de Setiba, localizada nos municípios de Guarapari e Vila Velha, região metropolitana de Vitória. A medida foi adotada em razão dos casos de gripe aviária registrados no estado e abrange, no total, oito ilhas.
O Arquipélago das Três Ilhas é formado por cinco ilhas: Quitongo, Cambaião, Guanchumbas, Leste-Oeste e Guararema. Nas demais áreas da APA estão as ilhas Francisco Vaz, Toaninha e Alacaeira. A portaria conjunta da Secretaria Estadual de Meio Ambiente e Recursos Hídricos e do Instituto Estadual de Meio Ambiente e Recursos Hídricos foi publicada nesta quinta-feira (8) em edição extra do Diário Oficial do estado.
O Espírito Santo é o estado com o maior número de casos de gripe aviária no país, com 20 focos de influenza aviária de alta patogenicidade (H5N1) confirmados. Até então, o Brasil nunca havia registrado ocorrência da doença em seu território.
Ao todo, 30 focos em aves silvestres já foram confirmados nos estados do Espírito Santo, Rio de Janeiro, Rio Grande do Sul, São Paulo e Bahia. A maioria é em aves das espécies Thalasseus acuflavidus (nome popular trinta-réis-de-bando) e Thalasseus maximus (trinta-réis-real).
O Ministério da Agricultura e Pecuária disponibilizou um painel para consulta de casos confirmados, descartados e em investigação. A plataforma pode ser consultada por qualquer pessoa e será atualizada duas vezes ao dia, às 13h e às 19h.
Nesta semana, o governo federal também abriu crédito extraordinário de R$ 200 milhões em favor do Mapa para ações de enfrentamento à gripe aviária. A pasta informou que, com o estado de emergência zoossanitária em vigor no país, as ações de controle e contenção serão intensificadas para evitar que a doença chegue à produção de aves de subsistência e comercial, além de preservar a fauna e a saúde humana.
A orientação do Mapa é que a população não recolha aves que encontrar, doentes ou mortas, e acione o serviço veterinário mais próximo. Ainda segundo o governo, não há mudanças no status brasileiro de livre da influenza aviária de alta patogenicidade perante a Organização Mundial de Saúde Animal, por não haver registro na produção comercial.
A doença
A influenza aviária é uma doença viral altamente contagiosa que afeta principalmente aves domésticas e silvestres. Ela é caracterizada principalmente pela alta mortalidade de aves que pode ser acompanhada por sinais clínicos, tais como andar cambaleante, torcicolo, dificuldade respiratória e diarreia.
O vírus H5N1 não infecta humanos com facilidade, mas o aumento de casos recentemente deixou as autoridades sanitárias do mundo todo em alerta. As infecções humanas podem acontecer por meio do contato com aves infectadas, vivas ou mortas, ou ambientes contaminados com secreções respiratórias, sangue, fezes e outros fluidos liberados no abate das aves.
O risco de transmissão às pessoas por meio de alimentos devidamente preparados e bem cozidos também é muito baixo. Além disso, a transmissão de pessoa para pessoa não é sustentada, ou seja, por enquanto, o vírus não se espalha facilmente de pessoa para pessoa.
Apesar de ser pouco frequente, em humanos, a gripe aviária pode ser grave, com alta taxa de mortalidade. O Instituto Butantan, em São Paulo, começou a desenvolver uma vacina contra a doença [], devido à preocupação de que ela possa se tornar uma nova pandemia.